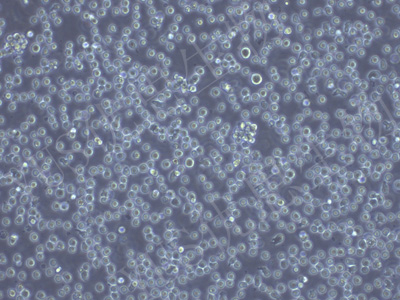

产品中心
产品中心
-

NCI-H2122 人肺癌细胞(STR鉴定)
货号:YLH642规格: 1*10^6 -

Marcus 人星形胶质细胞瘤(STR鉴定)
货号:YLH643规格: 1*10^6 -

MES-SA 人子宫肉瘤细胞(STR鉴定)
货号:YLH644规格: 1*10^6 -

COLO-680N 人食管鳞状细胞癌(STR鉴定)
货号:YLH645规格: 1*10^6 -

GCT 人巨细胞瘤细胞(STR鉴定)
货号:YLH646规格: 1*10^6 -

REC-1 人非霍奇金淋巴瘤细胞(STR鉴定)
货号:YLH647规格: 1*10^6 -

MOG-G-UVW 人脑星形胶质细胞瘤细胞(STR鉴定)
货号:YLH648规格: 1*10^6 -
JM-1 人B淋巴母细胞瘤细胞(STR鉴定)
货号:YLH649规格: 1*10^6 -

SW962 人阴户磷癌细胞(STR鉴定)
货号:YLH650规格: 1*10^6 -

BFTC-905 人膀胱移行细胞癌细胞(STR鉴定)
货号:YLH651规格: 1*10^6 -

TE-14 人食管鳞状细胞癌细胞(STR鉴定)
货号:YLH654规格: 1*10^6 -

NCI-H2171 人肺癌细胞(STR鉴定)
货号:YLH655规格: 1*10^6
在线咨询
Online consultation

关注微信公众号


